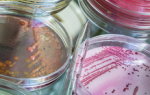

Определение: Туберкулезная интоксикация – это самостоятельная безлокальная клиническая форма первичного туберкулеза, характеризующаяся комплексом нерезко выраженных функциональных нарушений в организме ребенка или подростка в результате наличия активной инфекции. Эта форма возникает в период виража туберкулиновой пробы как следствие недавнего инфицирования. Удельный вес этой формы среди первичного туберкулеза составляет 2-5%.
Различаютраннюю и хроническую туберкулезную интоксикацию.
Ранняя – возникает в первый год виража туберкулиновой пробы. Хроническая туберкулезная интоксикация проявляется в более поздние сроки (спустя год и более после инфицирования). Хроническая туберкулезная интоксикация, как правило, связана с поздним выявлением.
В 1919 году А.А. Кисель предложил термин «туберкулезная интоксикация» для обозначения туберкулезного заболевания у детей, при котором преобладает общие расстройства, а морфологические изменения в органах столь малы, что недоступны выявлению. Он впервые описал туберкулез как общее заболевание, разработал учение о хронической туберкулезной интоксикации как о своеобразном сложном хроническом синдроме, отражающем патологическое состояние нервной системы, лимфатического, кроветворного аппаратов, обмена веществ под влиянием туберкулезной инфекции.
Ранняя туберкулезная интоксикация чаще встречается у детей дошкольного возраста. Клинические проявления туберкулезной интоксикации отличаются большим многообразием.
Выявляется неврологическая симптоматика: раздражительность, плаксивость, быстрая утомляемость, беспокойный сон или, наоборот, сонливость, субфебрильная температура тела, головные боли, ребенок теряет жизнерадостность, подвижность.
Отмечается комплекс функциональных нарушений со стороны некоторых органов под масками других заболеваний. Заболевание может напоминать ревмокардит: появляются боли в сердце, сердцебиение, изменения на ЭКГ, боли в суставах. Могут быть симптомы поражения бронхолегочного аппарата: кашель, жесткое дыхание, сухие хрипы, усиление прикорневого рисунка на рентгенограмме – маска бронхита. Симптомы поражения желудочно-кишечного тракта – ухудшение аппетита, похудание, диспепсические проявления. Такие функциональные расстройства неспецифичны и связаны с особенностями реактивности организма детей, заключающиеся в превалировании общих нервных и сосудистых реакций над местными изменениями.
При обследовании ребенка следует обратить внимание на микрополиаденит. Лимфатические узлы мягкоэластической консистенции, безболезненные, подвижные, пальпируются 6-8 групп (шейные, подмышечные, затылочные, паховые и др.). В гемограмме повышена СОЭ, умеренный лейкоцитоз, палочкоядерный сдвиг влево, лимфопения, моноцитоз, эозинофилия. В моче могут наблюдаться изменения в виде небольшого количества белка, гематурии, лейкоцитоурии. На рентгенограмме очагов в легких и увеличенных внутригрудных лимфатических узлов не обнаруживают.
Диагноз ранней туберкулезной интоксикации устанавливать чрезвычайно сложно. Предварительно необходимо исключить другие заболевания. Лечение ранней туберкулезной интоксикации проводится в течение 4-6 месяцев двумя противотуберкулезными препаратами в сочетании с витаминами, полноценным питанием. При таком подходе в 5 раз реже отмечается переход в хроническую туберкулезную интоксикацию.
Хроническая туберкулезная интоксикация чаще встречается у детей школьного возраста, протекает длительно, что отражается на физическом развитии детей. Характерными симптомами являются те же функциональные расстройства, что и при ранней туберкулезной интоксикации, но более длительно сохраняющиеся.
При объективном обследовании ребенка выделяют патогномоничный клинический симптомокомплекс:
— отставание в весе, росте, слабое развитие подкожной клетчатки и мышечной системы;
В цитологической картине пунктатов периферических лимфоузлов выявляются лимфоидные и эпителиоидно-клеточные бугорки с участками микроказеоза или без него, иногда наличие фиброза, что характеризует различные фазы специфического процесса.
Дифференцировать туберкулезную интоксикацию необходимо с хроническим тонзиллитом, глистной инвазией, хроническим гайморитом, ревмокардитом, холециститом и др.
При длительном рентгенологическом наблюдении за детьми, страдающими хронической интоксикацией, почти в половине случаев выявляются мелкие кальцинаты во внутригрудных лимфатических узлах. Из этого следует, что симптомокомплекс хронической туберкулезной интоксикации связан преимущественно с длительно текущей малой формой туберкулеза внутригрудных лимфатических узлов, которая вовремя не была распознана и выявлена только в период отложения кальция в лимфоузлах.
Лечение детей хронической туберкулезной интоксикацией проводят в санаторных школах двумя противотуберкулезными препаратами в течение 5-6 месяцев в сочетании с общеукрепляющей и десенсибилизирующей терапией. Дети, получившие химиотерапию в 5 раз реже заболевают локальными формами туберкулеза.
Диагноз туберкулезной интоксикации должен базироваться на следующих признаках:
— виража туберкулиновой пробы;
— контакта с бактериовыделителем;
— положительной пробе Коха;
— положительного эффекта от специфической химиотерапии;
— осмотре ребенка ЛОР-врачом, иногда ревматологом, санации очагов инфекции (тонзиллита, аденоидов, дегельминтизация). Однако после лечения этих заболеваний симптомы интоксикации сохраняются, а эффект достигается применением пробной специфической терапии в течение 3 месяцев.
Поиск локализации туберкулезного очага обязателен. Необходимо выполнить срединную томограмму для исключения малой формы туберкулеза внутригрудных лимфатических узлов, УЗИ брюшной полости для выявления увеличенных мезентериальных и забрюшинных лимфатических узлов, бронхоскопию – для выявления специфического эндобронхита. И, если после дообследования туберкулезных изменений в органах не выявляют, то выставляется диагноз согласно клинической классификации: Ранняя (хроническая) туберкулезная интоксикация. Эта клиническая форма туберкулеза имеет место только у детей и подростков.
Туберкулезная интоксикация в большинстве случаев заканчивается выздоровлением. Но в ряде случаев протекает длительно, волнообразно, что может привести к развитию локального первичного туберкулеза.
Не нашли то, что искали? Воспользуйтесь поиском:
Туберкулезная интоксикация – форма туберкулеза, развивающаяся в результате первичного контакта с микобактериями. Причинами интоксикации являются прямой или опосредованный (через посуду, полотенца, зубные щетки) контакт с больным активной формой болезни. Чаще болеют дети и подростки. Доля этой патологии в общей структуре первичных форм заболевания не превышает 12%. Диагноз ставится только при выраженной положительной реакции Манту.
Симптомы
Заболевание отличается неспецифической клинической картиной и отсутствием выраженных очагов инфекции в органах. Для картины туберкулезной интоксикации характерны общие симптомы инфекции и признаки аллергической реакции. Такие симптомы, как кашель, одышка, кровохарканье и боль в груди отсутствуют.
Ранняя туберкулезная интоксикация – это начальный период болезни, развивающийся на фоне свежего (первичного) заражения микобактериями. Возможны следующие симптомы:
- Раздражительность.
- Постоянная головная боль.
- Расстройства сна (частые пробуждения в ночное время, неспокойный сон, трудность засыпания).
- Субфебрильная температура (не превышает 38ºC).
- Ночная потливость.
- Плохой аппетит.
- Быстрая утомляемость при умственной и физической работе.
- Снижение успеваемости в школе.
- Лимфоаденопатия (увеличение периферических лимфатических узлов). Становятся мягкоэластической консистенции. Чаще всего поражается сразу несколько групп лимфоузлов (подмышечные, шейные, паховые).
- Диспепсия. У детей возможны нарушения стула (запор или диарея) и боль в эпигастральной или околопупочной зоне.
- Увеличение печени и селезенки. Чаще наблюдается у людей худощавого телосложения.
- Узловатая эритема. На теле (чаще всего на нижних конечностях) образуются плотные узлы величиной до 4-5 см. Они располагаются глубоко под кожей. Наблюдаются боль и болезненность. Кожный зуд отсутствует. Через несколько дней происходит их разрешение с образованием участков уплотнения тканей. Начало появления узловатой эритемы сопровождается лихорадкой, ознобом, болью в суставах и общим недомоганием.
Первая стадия интоксикации длится около 4-6 недель. По ее завершении возникает вираж туберкулиновой пробы (впервые выявленная положительная реакция на введение туберкулина).
Признаками хронической туберкулезной интоксикации являются:
- Постоянная усталость, не исчезающая при длительном отдыхе.
- Психоэмоциональные нарушения (раздражительность, плаксивость, неустойчивость настроения).
- Вегетативные расстройства (перепады давления, неустойчивый стул, частое сердцебиение, потливость).
- Нарушение сна.
- Сердечно-сосудистые расстройства (склонность к снижению артериального давления, шум в области сердца).
- Снижение массы тела.
- Увеличение сразу 6-9 групп лимфатических узлов.
- Частые воспалительные заболевания глаз (воспаление конъюнктивы и роговицы).
- Диспепсия.
- Отставание детей в физическом развитии.
- Периодическое умеренное повышение температуры.
Диагностика
При подозрении на туберкулезную интоксикацию у детей и подростков следует обратиться к врачу (педиатру). Затем пациента должен осмотреть фтизиатр, который знает все особенности патологии. Для уточнения диагноза и исключения другой патологии понадобятся:
- Сбор анамнеза. Позволяет установить основные жалобы, давность болезни и факторы риска.
- Физикальный осмотр. Проводятся перкуссия, пальпация и выслушивание легких и сердца.
- Внешний осмотр. Осматривают кожу и слизистые.
- Общий анализ крови. Выявляют лейкоцитоз (увеличение лейкоцитов в крови), ускорение СОЭ, увеличение эозинофилов, повышение лимфоцитов и сдвиг лейкоцитарной формулы влево.
- Бронхоскопия.
- Компьютерная томография. Позволяет послойно изучить состояние мягких тканей.
- Бактериологическое исследование мокроты.
- Исследование смывов. Не выявляет микобактерий.
- Проба Манту. На хроническую интоксикацию указывает нарастание реакции на введение туберкулина через год после первой положительной пробы Манту.
- Диаскинтест.
- Микроскопия.
- Полимеразная цепная реакция.
- Рентгенография. Не выявляет очагов специфического (гранулематозного) воспаления легких в виде теней. Возможны усиление легочного рисунка и образование кальцинатов (солевых отложений).
Диагноз подтверждается по результатам лабораторных исследований. Дифференциальная диагностика проводится с другими инфекционными заболеваниями, туберкулезом внутригрудных лимфатических узлов и первичным туберкулезным комплексом.
Лечение
Взрослых больных и детей, находящихся дома, в детском саду или школе, госпитализируют в противотуберкулезный стационар. Лечение туберкулезной интоксикации у детей и подростков преимущественно медикаментозное. Применяются следующие антибактериальные препараты:
- Стрептомицин (Стрептомицин-КМП). Используется в форме порошка, из которого готовится раствор для внутримышечного введения. Это антибиотик широкого спектра из группы аминогликозидов. Противопоказаниями к назначению лекарства являются непереносимость компонентов, миастения, облитерирующий эндартериит, тяжелая почечная и сердечно-сосудистая недостаточность, поражение 8 пары черепных нервов, нарушение церебрального кровообращения.
- Рифампицин (Макокс, Фарбутин, Римпин). Противотуберкулезное средство первой линии. Лекарство не назначается при непереносимости, инфекционном гепатите в анамнезе, желтухе и дисфункции почек. При патологии печени и истощении лекарство используют с осторожностью.
- Пиразинамид (Пиразинамид-Никка, Пизина). Противотуберкулезный препарат 2 ряда. Не назначается при дисфункции печени и повышенной чувствительности. Дозировка для детей и взрослых одинаковая. Препарат принимают внутрь после еды.
- Этамбутол (Этамбусин, Екокс, ЕМБ-Фатол 400). Назначается с 13 лет. Выпускается в форме таблеток. Антибиотик противопоказан при непереносимости, диабетической ретинопатии, помутнении хрусталика, неврите зрительного нерва, воспалении структур глаза, подагре и тяжелой почечной недостаточности.
- Изониазид (таблетки и раствор для инъекций).
- Комбинированные средства. К ним относятся Изокомб (назначается с 13 лет) и Фтизоэтам (с 12 лет).
Дополнением к основной терапии являются прием десенсибилизирующих (противоаллергических) средств и витаминов, полноценное питание, обильное питье, физиопроцедуры, дыхательные упражнения и санаторно-курортное лечение. После лечения больные подлежат диспансерному наблюдению.
Прогнозы
При своевременном и полноценном лечении прогноз благоприятный. Большинство больных выздоравливают. При отсутствии лечения или поздней диагностике могут развиться:
Нередко поражаются другие органы (кишечник, головной мозг, глаза, кожа, кости).
Туберкулёз у многих людей ассоциируется с тяжёлым неизлечимым инфекционным заболеванием лёгких или верхних дыхательных путей. Подвержены этой болезни не только асоциальные слои населения или лица, находившиеся в заключение, такой процесс поражает, в том числе и детей. Заразиться, может, абсолютно любой человек, независимо от социальной принадлежности. А самое опасное — это тяжёлые осложнения и необычные формы течения болезни, когда в процесс вовлекаются все внутренние органы.
Что это такое — туберкулёзная интоксикация? В каких случаях выставляется именно этот диагноз и что делать, если в семье есть такой больной?
Что такое туберкулёзная интоксикация
Туберкулёзная интоксикация — это термин, обозначающий развитие туберкулёзной инфекции при невозможности установления точной локализации. То есть когда все анализы при прохождении обследования указывают на присутствие и размножение микобактерий в организме, а конкретное нахождение возбудителя установить нельзя. Такой диагноз чаще звучит в детском и подростковом возрасте, для взрослых характерны другие состояния. У них это скорее не отдельная форма заболевания, а синдром, характерный для поздних запущенных стадий болезненного процесса. Симптоматика людей старшего возраста нередко напоминает отравление.
Диагностика туберкулёзной интоксикации
Туберкулёз легко диагностировать, если болезнь в самом разгаре. Классическое проявление туберкулёза — кашель, слабость, длительное повышение температуры и постоянное недомогание. Но в период инфицирования, когда организм только встретился с инфекцией проявления скудные. Вот почему на первых этапах она практически никогда не диагностируется. Насторожить медработников могут следующие моменты.
Если в семье есть инфицированные люди.
- В процессе ежегодной проверки у детей выявляется положительная туберкулиновая проба. Это метод диагностики не только туберкулёзной интоксикации, но и других форм заболевания.
- Заподозрить заболевание можно в случае, когда у ребёнка или взрослого человека постоянно увеличены лимфоузлы и в анализе крови появляются признаки воспаления.
- Ежегодное флюорографическое исследование показывает неспецифические изменения в лёгких и окружающих тканях.
- На более поздних стадиях, в период ярких проявлений туберкулёзную интоксикацию у детей и взрослых можно установить на основании симптомов.

В настоящее время такой диагноз выставляется в редких случаях. Различают раннюю и хроническую формы инфекции. Для каждого варианта туберкулёзной интоксикации характерны свои симптомы.
- Раннее течение туберкулёзной инфекции проявляется раздражительностью или заторможенностью, общим недомоганием, повышенной нервной возбудимостью, головной болью, отсутствием аппетита, учащённым сердцебиением. Но по таким признакам тяжело заподозрить начинающееся заболевание, ведь они характерны для многих процессов. Поэтому нередко устанавливается диагноз туберкулёзной интоксикации уже на хронической стадии.
Позже болезнь проявляется увеличением практически всех форм лимфоузлов до незначительных размеров, всего 0,5—1,5 см. Они плотные и болезненные при обследовании.
- Периодическое незначительное повышение температуры тела.
- Для хронической туберкулёзной интоксикации характерно небольшое увеличение печени или селезёнки во время обследования внутренних органов.
- Выраженная утомляемость, снижение работоспособности.
- Возникновение интеркуррентных заболеваний. Это те болезненные процессы, которые появляются на фоне основной болезни, не связанные с ней.
- В общем анализе крови появляются постоянные изменения, характерные для туберкулёзной инфекции: увеличение скорости оседания эритроцитов, снижением лимфоцитов, повышением количества эозинофилов и нейтрофилов.
Для постановки диагноза делают общий анализ крови, рентгенографический снимок в прямой и боковых проекциях, проводят исследование мокроты с определением специфических клеток.
Туберкулёзная интоксикация у детей и подростков
Такой диагноз в последние годы звучит всё реже. Выставить болезнь помогают ежегодные туберкулиновые пробы и неоднократная положительная реакция на них. Туберкулёзная интоксикация у детей и подростков имеет свои незначительные особенности.
Кроме общих симптомов, наблюдается остановка физиологической прибавки массы тела либо резкий её дефицит. До года у ребёнка каждый месяц измеряется масса тела, после года это делают один раз в 12 месяцев. Показатели прибавки варьируют незначительно, у заражённых детей её не наблюдается.
- Дети склонны к бронхоадениту (увеличение группы лимфоузлов в области рядом с бронхами), поэтому на рентгенограмме чаще выявляется воспаление в этой области.
- По кровеносной системе микобактерии распространяются во все органы, дети склонны с тяжёлым осложнениям: туберкулёзный менингит и милиарный туберкулёз.
Заразна ли туберкулёзная интоксикация у детей? До момента начала лечения, в период активных проявлений любая инфекция может распространиться. В этот период дети могут заразить окружающих.
Туберкулёзная интоксикация у взрослых

Симптоматика туберкулёзной интоксикации у взрослых напоминает острое инфекционное заболевание. Проявляется слабостью, повышением температуры, резкой и выраженной утомляемостью, нарушением сознания в далеко зашедших стадиях. В остальном основное заболевание протекает без особенностей.
Лечение туберкулёзной интоксикации
Лечение туберкулёзной интоксикации у всех групп заражённых людей проводится длительным курсом с обязательным назначением противотуберкулёзных препаратов. Дети и подростки хорошо переносят химиотерапию, поэтому её назначают таким же режимом, как и у взрослых людей.
Интоксикация при туберкулёзе и туберкулёзная интоксикация — это разные процессы. Первый обозначает реакцию организма на инфекцию, второй — течение туберкулёза у детей. Любой из этих процессов подлежит наблюдению врачей и обязательному длительному лечению. Сами по себе эти состояния не излечиваются и не проходят.

Туберкулез — тяжелое заболевание инфекционного характера с высокой степенью заразности за счет способности распространяться воздушно-капельным путем. При наличии нарушений в иммунной системе заболеть могут люди из абсолютно разных социальных групп. Не всегда туберкулез — отражение асоциального образа жизни. У него существует несколько вариантов развития, один из них — туберкулезная интоксикация (проявление детского течения болезни).
Туберкулезом легких занимаются специалисты направления пульмонологии с применением специфических методов диагностики.
Причины развития
Классический вариант развития заболевания у взрослых и детей — легочная форма, характеризующаяся скоплением микобактерий (МБТ) с образованием туберкулем. Данные изменения регистрируются при помощи рентгена.
Туберкулезная интоксикация в большей степени определяет общую реакцию организма на внедрение микобактерий. Подобный вариант, а также туберкулезное поражение ВГЛУ (внутригрудных лимфатических узлов) и первичный туберкулезный комплекс (ПТК) распространен у детей и подростков. Для постановки диагноза пульмонологам требуются лабораторные исследования, положительная реакция диагностических тестов (проба Манту, диаскинтест), данные осмотра и анамнеза в сочетании с отсутствием специфических изменений в легких по данным флюорографии или рентгенографии.
При первом контакте с палочкой Коха в 5% случаев возможно развитие туберкулезной интоксикация у детей и подростков. Источником инфицирования первичной формы туберкулеза является человек с открытым вариантом инфекции, когда каверна связана с дренирующим бронхом. В таком случае во время разговора, кашле МБТ попадают в окружающую среду.
Затем при вдыхании зараженного воздуха палочки Коха оказываются в легких, но специфических туберкулезных изменений не возникает. Они мигрируют в лимфатические узлы, где уже провоцируют воспаление. Далее отмечается массивное распространение по всему организму с формированием признаков отравления с учетом особенностей туберкулеза.
Так возникает клиническая форма первичного туберкулеза, подозревать которую возможно не столько по симптомам, сколько по результатам диагностики — проба Манту, Диаскинтест, бакпосев мазка.
Первые симптомы и дальнейшая диагностика туберкулезной интоксикации
Туберкулезная интоксикация провоцируется первичным инфицированием микобактериями туберкулеза. Признаком ранней реакции служит положительная туберкулиновая проба Манту. Дополнительным диагностическим тестом служит Диаскинтест, обладающий повышенной чувствительностью к МБТ.
Особенность данного патологического процесса — отсутствие изменений в легких по данным рентгенологических исследований.
Для подтверждения факта туберкулезной интоксикации применяется следующие алгоритм:
- Полный осмотр и опрос ребенка и родителей для исключения неспецифических воспалительных заболеваний со схожей клинической картиной. А также для выявления наличия возможного контакта с носителем туберкулеза.
- Проведение туберкулинопровокационных проб.
- Применение лучевых методов диагностики (рентгенография или компьютерная томография, ультразвуковая диагностика) для исключения локализации очагов туберкулеза на уровне органов брюшной полости или в группах лимфоузлов средостения. При необходимости возможно проведение бронхоскопии с последующим бакпосевом полученного мазка.
- Использование лабораторных методов исследования — общий анализ крови.
Туберкулезная интоксикация проявляется ухудшением состояния ребенка. Если рассмотреть основные диагностические показатели, то выглядят они следующим образом:
| Исследуемые критерии | Клинические проявления, характерные для туберкулезной интоксикации у детей и подростков |
| Общесоматические признаки ранней туберкулезной интоксикации у детей |
|
| Данные анализа крови |
|
| Проба Манту, Диаскинтест | Стойкая положительная реакция |
| УЗИ |
|
| Рентген, флюорография | Для картины туберкулезной интоксикации характерно отсутствие специфического поражения ткани легкого. |
На основании полученных данных врач-пульмонолог или фтизиатр осуществляет дифференциальную диагностику с заболеваниями, которые сопровождаются схожим интоксикационным синдромом.
https://youtube.com/watch?v=ew4Ju3Rk8tc
При подтверждении диагноза туберкулезной интоксикации устанавливают группу наблюдения и дают направление на специализированное лечение.
Тактика лечения и профилактические мероприятия
Лечением туберкулезной интоксикации у детей занимаются в специализированных противотуберкулезных стационарах. Терапия основывается на основных принципах:
- В качестве первой помощи — десенсибилизирующая терапия, направленная на уменьшение признаков интоксикационного синдрома.
- Противотуберкулезные химиопрепараты — изониазид, рифампицин, этамбутол или пиразинамид.
- Витаминотерапия.
Длительность курса — до 1 года, но не меньше 6 месяцев. Для полноценного восстановления защитных свойств организма программу лечения дополняют немедикаментозными методами (дыхательная гимнастика, физиотерапия), составляют схему здорового питания.
Посещение обычного дошкольного учреждения в период активного лечения запрещено, но альтернативой является сад для детей с туберкулезной интоксикацией.
С профилактической точки зрения родителям рекомендуют не отказываться от обязательной вакцинации, что сформирует специфическую сенсибилизацию. Также стоит проходить периодические туберкулинодиагностические тесты. При возникновении виража туберкулиновой пробы (гиперэргической реакции на туберкулин) в сочетании с признаками интоксикации следует незамедлительно обращаться к специалистам. Самостоятельное лечение может быть крайне опасным.
Вовремя диагностированная форма первичного туберкулеза, дополненная полноценно составленной программой лечения завершается благоприятным исходом — выздоровлением. Но при невыполнении лечебных рекомендаций развивается хроническая туберкулезная интоксикация у детей, а также резко возрастает опасность ограниченного туберкулезного внелегочного поражения.

Диагностированные заболевания туберкулезом у детей – это чаще всего как раз первичные случаи заражения микобактериями, а среди подростков они составляют 10-20% от общего числа. Клиническая картина, свойственная первичному туберкулезу, редко бывает у пожилых людей, и, как правило, это результат возросшей активности микобактерий, которые были подавлены ранее.
В 90-95% случаев инфицирования туберкулезными бактериями болезнь не развивается, инфицирование сопровождается небольшими неспецифическими изменениями с формированием устойчивого пожизненного иммунитета. Но у носителей вируса иммунодефицита, а также людей, не привитых или неправильно привитых БЦЖ, туберкулез может перейти в активную форму.
- Туберкулезная интоксикация
- Туберкулез внутригрудных лимфоузлов
- Первичный туберкулезный комплекс
Способ передачи и симптоматика
Бактерии, вызывающие заболевание, попадают в организм чаще всего аэрогенно, реже – через ЖКТ или при тактильном контакте. Задерживаются и размножаются они в альвеолах – нижней части дыхательного аппарата, по виду напоминающего пузырьки.
Некоторые бактерии попадают в лимфу и кровь, а с током этих жидкостей – в органы, где много макрофагов – клеток, отвечающих за уничтожение чужеродных и токсичных частиц в организме человека.
Особенности первичного туберкулеза, отличающие его от вторичного инфицирования микобактериями, следующие:
- бурное начало,
поражение 3 и 5-9 сегментов легких,
- вовлечение в процесс болезни лимфатической системы (узлов и сосудов),
- высокая чувствительность кожной ткани к туберкулиновым пробам,
- развитие плеврита,
- присутствие микобактерий в лимфе и крови,
- преимущественно доброкачественное течение заболевания вплоть до самоизлечения.
Первые симптомы, проявляющиеся у ребенка и подростка, имеют важнейшее значение при дальнейшей диагностике на всех этапах первичного туберкулеза. Следует обратить внимание на следующие изменения:
- Поведение. Пропадает типичная для ребенка жизнерадостность и подвижность. Он становится плаксивым и капризным.
- Нарушение сна, быстрая утомляемость в дошкольном возрасте. У школьников ухудшается память, снижается внимание, показатели в учебе становятся ниже.
- Снижение аппетита, а, следовательно, массы тела.
- Боли мышц и суставов, когда патологических изменений в этих тканях не обнаруживается.
- Изменения температуры. Температура тела часто колеблется в течение суток в пределах субфебрильной – на активной стадии заболевания. Но может не превышать норму, а по утрам – снижаться до минимальных отметок. При менингите туберкулезной природы или экссудативном плеврите стабильно наблюдается повышенная температура – 39-40 градусов.

И только при поражении легких и их деструктивном изменении присутствует мокрота, возможны в редких случаях выделения гноя и крови.
Характер мокроты. При начале заболевания отсутствует, по мере развития первичного туберкулеза ее объем может увеличиваться, при этом откашливается она с трудом. Затруднение дыхания. Отмечается не всегда. При обширных поражениях легких развивается в результате действия бактерий органы дыхания и раздражения рецепторов легких и плевры. Боли при вдохе. Локализация – грудная клетка, развиваются при поражении плевры. Сильная потливость, особенно по ночам, может быть признаком заболевания.
Формы первичного туберкулеза
Первичный туберкулез локализуется, как правило, в лимфатических узлах и легких, реже – в почках, суставах, брюшной области, костной ткани.

- Туберкулез неустановленной локализации (туберкулезная интоксикация).
- Туберкулез внутригрудных лимфоузлов.
- Первичный туберкулезный комплекс.
Деятельность микобактерий в организме провоцирует его на иммунный ответ в виде формирования особого клеточного иммунитета. При неправильном балансе реакций возникает избыточное производство веществ, повреждающих клеточные мембраны и вызывающих нарушение метаболизма в клетках. В результате вырабатываются токсины, которые с током крови разносятся по органам и вызывают интоксикационный синдром, являющийся признаком первичного туберкулеза.

- вираж туберкулиновой пробы (резкое изменение реакции в сторону ее усиления),
- небольшие воспаления с неявной локализацией.
Туберкулезная интоксикация не диагностируется рентгенологически, для этого делается обзорная рентгенограмма или срединная томограмма.
Часто интоксикационный синдром завершается выздоровлением, пораженные участки превращаются в соединительную ткань, воспаление стихает, а казеоз (измененная структура тканей) нейтрализуется солями кальция. Микобактерии трансформируются в неактивную форму, которая поддерживает противотуберкулезный иммунитет, но, с другой стороны, может стать причиной его реактивации при сильном снижении общего иммунитета.
Если лечение не проводится, интоксикация может стать хронической. При прогрессировании заболевания микобактерии поражают лимфатическую систему, попадая во внутригрудные отделы. Далее туберкулез переходит и в другие лимфоузлы, их поражает частичный или тотальный казеоз, который охватывает окружающие клетки, сосуды и бронхи.
Такая форма получила название туберкулеза внутригрудных лимфатических узлов, она наиболее распространена среди зарегистрированных форм первичного туберкулеза.
Вследствие естественного тока лимфы болезнь редко распространяется за пределы бронхов и не затрагивает легкие. По мере прогрессирования воспаления лимфоидная ткань превращается в грануляции и, увеличиваясь, способна распространиться почти на весь лимфоузел. Локальное поражение может быть значительным.

Воспаление проходит, казеоз кальцинируется, лимфоузлы принимают нормальное состояние. Излечение длительное, составляет 2-3 года. Осложнение данной формы заболевания – поражение ткани легких.
Первичный туберкулезный комплекс – наиболее тяжелая форма первичного туберкулеза, которая может затрагивать легкие, кишечник и другие органы. Развивается она при серьезных нарушениях в работе иммунной системы.
Обычно такая клиническая форма возникает при общении с близким родственником, инфицированным открытой формой заболевания. Такой туберкулез развивается при низком иммунитете и сильной инфекции, переданной воздушно-капельным путем.
Стадии развития данной формы туберкулеза:
микобактерии грудного отдела переходят в место входных ворот легких,
- в легких образуется очаг воспаления (первичный аффект),
- инфекция распространяется через лимфатические сосуды на региональные лимфоузлы, происходит их воспаление.
Первичный туберкулезный имеет 3 обязательные составляющие:
- первичный аффект легочной ткани,
- лимфангит – воспаление отводящих сосудов лимфы,
- лимфаденит – воспаление внутригрудных лимфоузлов.
Первичный аффект может иметь различные размеры и даже охватывать целую долю легкого. Участок воспаления может развиться в любых сегментах легочной ткани.
Если комплекс вовремя выявлен, и терапия проводится правильно, заболевание протекает без осложнений, через пару лет в месте пневмонии формируются кальцинаты, в лимфоузлах и легких их размер достигает 1 сантиметра.
Первичный туберкулезный комплекс редко имеет осложнения, в этом случае кальцинаты бывают множественными, затрагивают, помимо легких, другие органы, возможен плевроцирроз, рубцы на бронхах.
Диагностика и лечение
- Анамнез. При первичной консультации врача важно проверить больного на контакт с носителями микобактерий, что причисляет его к группе риска.
- Более точно на наличие инфекции укажут положительные туберкулиновые пробы (Манту, Диаскинтест), при этом участок реакции бывает обычно больше, чем при вторичном инфицировании.
- Исследование мокроты, при ее наличии, промывных вод бронхов и желудка у маленьких детей, глотающих мокроту, на микобактерии.
Пальпация. При пальпации обязательно проверяются периферические лимфоузлы, так как первичный туберкулез на всех этапах сопровождается их увеличением. При осмотре больного врач обращает внимание на влажность кожи, тонус мышц, уплотнение подкожной клетчатки.
- Перкуссия (простукивание). Простукивания легких могут выявить изменения тона при патологических изменениях ткани в виде очагов или грануляций. Небольшие изменения обнаруживаются с трудом.
- Аускультация. Внимание при прослушивании фонендоскопом уделяется подмышечным впадинам, междулопаточным областям, в этих местах звук изменяется чаще всего. У новорожденных детей необходимо совершать аускультацию при плаче или крике с активными дыхательными движениями. При туберкулезе легких часто встречается ослабленное дыхание в пораженной зоне.
- Рентгенологическое исследование. Именно по рентгенологическим данным ставится окончательный диагноз при многих формах туберкулеза. Однако первичные формы туберкулеза и небольшие увеличения лимфоузлов часто не просматриваются рентгеном. В этом случае используется метод КТ.
Лечение острого туберкулеза проходит в стационарных условиях при соблюдении диеты и режима. Продолжительность составляет от 6 до 12 месяцев. Лечение проводится в следующем порядке:
- трехкомпонентная химиотерапия – основной блок препаратов (Изониазид, Фтивазид, Рифампицин),
- патогенетическое лечение – нормализация обменных процессов,
- применение гормональных препаратов в виде аэрозолей при поражении бронхов (Будесонид),
- хирургическое вмешательство при позднем выявлении болезни.
После выписки из стационара больные находятся под наблюдением в противотуберкулезном санатории.
При своевременно начатом лечении рецидивы заболевания, как правило, не наступают и прогноз благоприятный.
Читайте также:





 Если в семье есть инфицированные люди.
Если в семье есть инфицированные люди. Позже болезнь проявляется увеличением практически всех форм лимфоузлов до незначительных размеров, всего 0,5—1,5 см. Они плотные и болезненные при обследовании.
Позже болезнь проявляется увеличением практически всех форм лимфоузлов до незначительных размеров, всего 0,5—1,5 см. Они плотные и болезненные при обследовании. Кроме общих симптомов, наблюдается остановка физиологической прибавки массы тела либо резкий её дефицит. До года у ребёнка каждый месяц измеряется масса тела, после года это делают один раз в 12 месяцев. Показатели прибавки варьируют незначительно, у заражённых детей её не наблюдается.
Кроме общих симптомов, наблюдается остановка физиологической прибавки массы тела либо резкий её дефицит. До года у ребёнка каждый месяц измеряется масса тела, после года это делают один раз в 12 месяцев. Показатели прибавки варьируют незначительно, у заражённых детей её не наблюдается. микобактерии грудного отдела переходят в место входных ворот легких,
микобактерии грудного отдела переходят в место входных ворот легких, Пальпация. При пальпации обязательно проверяются периферические лимфоузлы, так как первичный туберкулез на всех этапах сопровождается их увеличением. При осмотре больного врач обращает внимание на влажность кожи, тонус мышц, уплотнение подкожной клетчатки.
Пальпация. При пальпации обязательно проверяются периферические лимфоузлы, так как первичный туберкулез на всех этапах сопровождается их увеличением. При осмотре больного врач обращает внимание на влажность кожи, тонус мышц, уплотнение подкожной клетчатки.